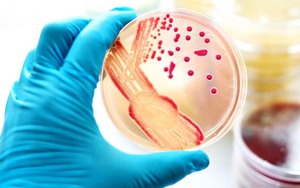
Chuyên gia y tế khuyến cáo các biện pháp phòng ngừa bệnh đậu mùa khỉ

Tag đậu mùa khỉ

WHO lo ngại về tình hình dịch bệnh đậu mùa khỉ tại CHDC Congo
Tin tức 24hNgày 13/1, Tổ chức Y tế Thế giới (WHO) cho biết tình hình dịch bệnh đậu mùa khỉ (mpox) ở Cộng hòa Dân chủ Congo vẫn đáng lo ngại, đồng thời dịch bệnh do virus nhóm Ib vẫn chủ yếu tập trung ở CHDC Congo, Burundi và Uganda.

Pháp phát hiện ca nhiễm biến thể mới của virus đậu mùa khỉ
Tin tức 24hBộ Y tế Pháp vừa thông báo phát hiện ca nhiễm đầu tiên của một biến thể mới virus đậu mùa khỉ, trong bối cảnh Tổ chức Y tế Thế giới (WHO) vẫn duy trì mức cảnh báo cao nhất đối với dịch bệnh này.

Roche tăng cường năng lực sản xuất bộ xét nghiệm đậu mùa khỉ
Tin tức 24hNgày 23/10, gã khổng lồ dược phẩm Thụy Sĩ Roche thông báo đang tăng cường năng lực sản xuất các bộ xét nghiệm chẩn đoán để phát hiện vius đậu mùa khỉ (mpox), trong bối cảnh các ổ dịch đang bùng phát mạnh trên khắp thế giới.

Singapore ghi nhận 13 ca mắc bệnh đậu mùa khỉ đều do chủng Clade 2
Tin tức 24hNgày 23/8, Bộ Y tế Singapore thông báo từ đầu năm đến nay, nước này đã ghi nhận 13 ca mắc bệnh đậu mùa khỉ (mpox). Tuy nhiên, tất cả các ca này đều nhiễm chủng Clade 2 của virus gây bệnh, vốn được đánh giá "ít nghiêm trọng hơn".

Na Uy, Hà Lan sẵn sàng ứng phó với bệnh đậu mùa khỉ
Tin tức 24hNgày 19/8, Bộ trưởng Y tế Na Uy Jan Christian Vestre cho biết hệ thống y tế nước này đã chuẩn bị tốt để ứng phó nguy cơ bùng phát dịch bệnh đậu mùa khỉ (mpox) sau khi quốc gia láng giềng Thụy Điển ghi nhận một ca mắc bệnh.

Phát hiện ca mắc bệnh đậu mùa khỉ đầu tiên bên ngoài châu Phi
Tin tức 24hNgày 15/9, Tổ chức Y tế Thế giới (WHO) đã xác nhận một trường hợp nhiễm virus gây bệnh đậu mùa khỉ ở Thụy Điển có liên quan đến đợt bùng phát dịch bệnh này ở châu Phi.

Những điều cần biết về đậu mùa khỉ mà WHO vừa ban bố trạng khẩn cấp
Tin tức 24hNgày 14/8, Tổ chức Y tế thế giới (WHO) đã ban bố trạng khẩn cấp về sức khỏe cộng đồng toàn cầu vì bệnh đậu mùa khỉ (mpox) ở châu Phi.

Cà Mau ghi nhận trường hợp bệnh đậu mùa khỉ đầu tiên
Tin tức 24hLiên quan đến trường hợp nghi ngờ mắc đậu mùa khỉ, ngày 29/2, thông tin từ Trung tâm Kiểm soát bệnh tật tỉnh Cà Mau cho biết đã có kết quả xét nghiệm từ Viện Pasteur Thành phố Hồ Chí Minh xác định bệnh nhân dương tính với bệnh đậu mùa khỉ.

Khu vực phía Nam ghi nhận 117 ca bệnh đậu mùa khỉ, 6 trường hợp tử vong
Tin tức 24hKhu vực phía Nam ghi nhận 117 ca đậu mùa khỉ tại 10 tỉnh, thành phố; trong đó có 6 bệnh nhân đã tử vong. Đậu mùa khỉ dự báo sẽ tiếp tục lây lan trong cộng đồng, chưa có dấu hiệu chững lại.

TP Hồ Chí Minh: Thêm nhiều trường hợp mắc đậu mùa khỉ
Tin tức 24hTheo báo cáo của Sở Y tế gửi cho UBND TP Hồ Chí Minh, từ đầu năm 2023 đến ngày 7/10, TP Hồ Chí Minh đã ghi nhận 13 trường hợp mắc bệnh đậu mùa khỉ.

Thành phố Hồ Chí Minh: Phát hiện ca bệnh đậu mùa khỉ thứ 5
Tin tức 24hThông tin từ Trung tâm Y tế quận Tân Bình, Thành phố Hồ Chí Minh, trên địa bàn quận vừa ghi nhận một ca bệnh đậu mùa khỉ (nam giới, 22 tuổi, đang tạm trú tại Phường 2).
Chuyên gia y tế khuyến cáo các biện pháp phòng ngừa bệnh đậu mùa khỉ
Tin tức 24hCơ quan y tế hai tỉnh Đồng Nai, Bình Dương cho biết đã ghi nhận ca mắc đậu mùa khỉ trên địa bàn. Trước mắt chưa xác định được nguồn lây nhiễm của ca bệnh. Như vậy, tính đến nay, cùng với 2 ca được phát hiện năm 2022, Việt Nam đã ghi nhận 4 trường hợp mắc bệnh đậu mùa khỉ.

Những lưu ý trong điều trị và phòng bệnh đậu mùa khỉ
Bạn cần biếtBệnh đậu mùa khỉ hiện đã xuất hiện tại nhiều quốc gia, trong đó có Việt Nam. Hiện Việt Nam đã ghi nhận 4 trường hợp mắc bệnh đậu mùa khỉ. Những người tiếp xúc gần nơi cư trú tại của ca bệnh tại TP Hồ Chí Minh hiện sức khỏe ổn định, không xuất hiện triệu chứng bất thường.

Số ca mắc đậu mùa khỉ ở Thái Lan tăng mạnh trong tháng 6
Tin tức 24hNgày 2/7, Cục trưởng Cục Kiểm soát Dịch bệnh thuộc Bộ Y tế Thái Lan, Tiến sĩ Tares Krassanairawiwong, cho biết nước này đã ghi nhận 48 trường hợp mắc bệnh đậu mùa khỉ vào tháng trước, tăng gấp 2,3 lần so với tháng 5.

WHO duy trì mức cảnh báo cao nhất đối với dịch đậu mùa khỉ
Tin tức 24hNgày 15/2, Tổ chức Y tế Thế giới (WHO) cho biết tiếp tục coi đợt bùng phát bệnh đậu mùa khỉ ở nhiều quốc gia là tình trạng khẩn cấp về sức khỏe cộng đồng gây quan ngại quốc tế (PHEIC), mức cảnh báo cao nhất của tổ chức này, với lý do dịch bệnh này tiếp tục lây lan ở một số quốc gia.

Thế giới năm 2022 căng mình ứng phó với nguy cơ “dịch chồng dịch”
Tin tức 24hThế giới vẫn đang cùng lúc ứng phó với hai dịch bệnh được Tổ chức Y tế thế giới (WHO) coi là "mối đe dọa nghiêm trọng đối với sức khỏe cộng đồng khi bùng phát trên toàn cầu": đại dịch COVID-19 và bệnh đậu mùa khỉ.

Bệnh nhân đậu mùa khỉ có thể truyền virus trước khi xuất hiện triệu chứng bệnh
Tin tức 24hTheo một nghiên cứu của các nhà khoa học Anh được đăng trên tạp chí BMJ số ra ngày 2/11, những người mắc bệnh đậu mùa khỉ có thể truyền virus 4 ngày trước khi xuất hiện các triệu chứng bệnh và hơn một nửa số ca lây nhiễm có thể diễn ra trong giai đoạn này.

Ca mắc bệnh đậu mùa khỉ thứ hai tại TP. HCM không có nguy cơ lây nhiễm cộng đồng
Tin tức 24hÔng Nguyễn Hồng Tâm, Phó Giám đốc điều hành Trung tâm Kiểm soát bệnh tật TP.HCM (HCDC) cho biết, theo tờ khai, 2 ca mắc đậu mùa khỉ ở cùng nhà tại Dubai.

Bệnh nhân mắc bệnh đậu mùa khỉ đầu tiên tại Việt Nam được xuất viện
Tin tức 24hNgày 14/10, thông tin từ Bệnh viện Bệnh Nhiệt đới Thành phố Hồ Chí Minh, bệnh nhân mắc đậu mùa khỉ đầu tiên tại Việt Nam được xuất viện sau 3 tuần cách ly, điều trị.

Hà Nội sẵn sàng đáp ứng khi có ca bệnh nghi ngờ đậu mùa khỉ
Tin tức 24hNhằm chủ động phòng, chống dịch bệnh đậu mùa khỉ, Phó Giám đốc Sở Y tế Hà Nội Vũ Cao Cương đã đề nghị khoa Kiểm dịch y tế quốc tế bổ sung thêm tờ rơi, pa nô truyền thông, khuyến cáo 2K phòng, chống dịch bệnh đậu mùa khỉ tại Khu vực kiểm dịch y tế quốc tế tại Cảng Hàng không quốc tế Nội Bài.
 Thời tiết
Thời tiết
Hà Nội
-
An Giang
-
Bình Dương
-
Bình Phước
-
Bình Thuận
-
Bình Định
-
Bạc Liêu
-
Bắc Giang
-
Bắc Kạn
-
Bắc Ninh
-
Bến Tre
-
Cao Bằng
-
Cà Mau
-
Cần Thơ
-
Điện Biên
-
Đà Nẵng
-
Đà Lạt
-
Đắk Lắk
-
Đắk Nông
-
Đồng Nai
-
Đồng Tháp
-
Gia Lai
-
Hà Nội
-
TP Hồ Chí Minh
-
Hà Giang
-
Hà Nam
-
Hà Tĩnh
-
Hòa Bình
-
Hưng Yên
-
Hải Dương
-
Hải Phòng
-
Hậu Giang
-
Khánh Hòa
-
Kiên Giang
-
Kon Tum
-
Lai Châu
-
Long An
-
Lào Cai
-
Lâm Đồng
-
Lạng Sơn
-
Nam Định
-
Nghệ An
-
Ninh Bình
-
Ninh Thuận
-
Phú Thọ
-
Phú Yên
-
Quảng Bình
-
Quảng Nam
-
Quảng Ngãi
-
Quảng Ninh
-
Quảng Trị
-
Sóc Trăng
-
Sơn La
-
Thanh Hóa
-
Thái Bình
-
Thái Nguyên
-
Thừa Thiên Huế
-
Tiền Giang
-
Trà Vinh
-
Tuyên Quang
-
Tây Ninh
-
Vĩnh Long
-
Vĩnh Phúc
-
Vũng Tàu
-
Yên Bái







